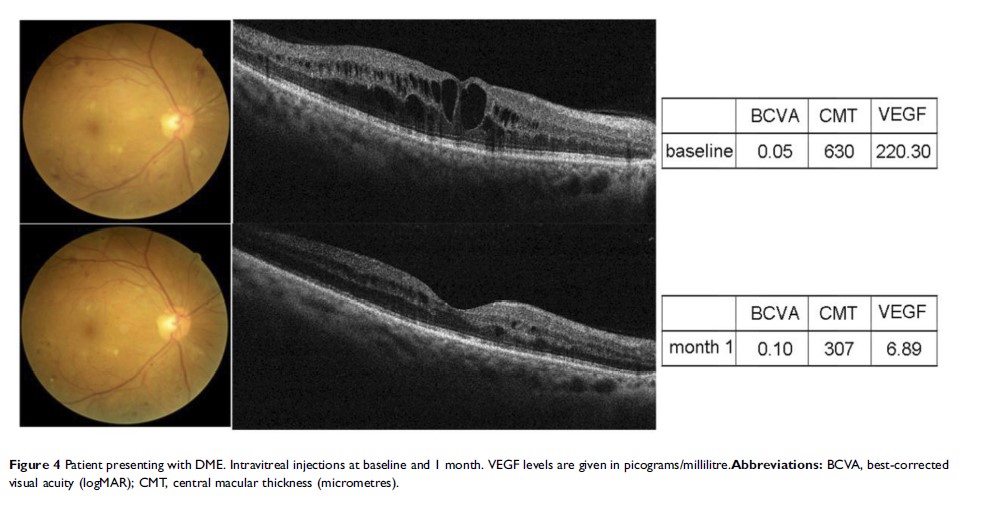

109451
论文已发表
注册即可获取德孚的最新动态
IF 收录期刊
- 3.4 Breast Cancer (Dove Med Press)
- 3.2 Clin Epidemiol
- 2.6 Cancer Manag Res
- 2.9 Infect Drug Resist
- 3.7 Clin Interv Aging
- 5.1 Drug Des Dev Ther
- 3.1 Int J Chronic Obstr
- 6.6 Int J Nanomed
- 2.6 Int J Women's Health
- 2.9 Neuropsych Dis Treat
- 2.8 OncoTargets Ther
- 2.0 Patient Prefer Adher
- 2.2 Ther Clin Risk Manag
- 2.5 J Pain Res
- 3.0 Diabet Metab Synd Ob
- 3.2 Psychol Res Behav Ma
- 3.4 Nat Sci Sleep
- 1.8 Pharmgenomics Pers Med
- 2.0 Risk Manag Healthc Policy
- 4.1 J Inflamm Res
- 2.0 Int J Gen Med
- 3.4 J Hepatocell Carcinoma
- 3.0 J Asthma Allergy
- 2.2 Clin Cosmet Investig Dermatol
- 2.4 J Multidiscip Healthc

-
Original Research
miR-492 通过靶向 GJB4 促进癌症的进展,它还是膀胱癌的新型生物标志物

- 作者:Kai Wang, Hang Lü, Hongchen Qu, Qingpeng Xie, Tao Sun, Ou Gan, Bin Hu
- 期刊:OncoTargets and Therapy
-
Original Research
吴茱萸碱通过触发内源性凋亡信号通路的激活来选择性地抑制多发性骨髓瘤细胞的生长

- 作者:Qing Fang, Siyi Jiang, Chengyuan Li
- 期刊:OncoTargets and Therapy
-
Original Research
一种基于外周血检查用于预测胶质瘤分级及预后的评分系统

- 作者:Yiyang Wu, Zimu Song, Kuisheng Sun, Shikuo Rong, Peng Gao, Feng Wang, Tao Sun
- 期刊:OncoTargets and Therapy
-
Original Research
玻璃体内注射康柏西普治疗糖尿病性黄斑水肿后,患者细胞因子和趋化因子的变化
- 作者:Qingquan Wei, Zhongqi Wan, Yongcheng Hu, Qing Peng
- 期刊:Drug Design, Development and Therapy
-
Original Research
胸腔放疗有利于发生远处转移的广泛期小细胞肺癌老年患者

- 作者:Jing Qi, Liming Xu, Jian Sun, Xin Wang, Lujun Zhao
- 期刊:Cancer Management and Research
-
Original Research
涎腺小细胞癌的临床病理特征和生存率:一项基于人群的研究

- 作者:Jinbo Bai, Fen Zhao, Shuang Pan
- 期刊:Cancer Management and Research